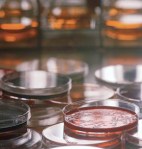
MH900407492

We perceive bacterial infections to be little more than a nuisance—with a  simple fix of taking an antibiotic for a few days and then we’re back to feeling one hundred percent. Fortunately, that’s usually the case.
simple fix of taking an antibiotic for a few days and then we’re back to feeling one hundred percent. Fortunately, that’s usually the case.
Certain bacteria, however, have become resistant to many commonly used antibiotics and that can make these little bugs much more ominous. When infectious bacteria become resistant to treatment, they’re labeled as SUPERBUGS.
The SUPERBUG phenomenon occurs with overuse or improper use of antibiotic therapy, and the problem isn’t confined to hospitals or other institutional settings. Simple infections of the skin, urinary tract, ear and lungs are increasingly more stubborn to cure and often require stronger antibiotics than in the past or require combinations of drugs.
therapy, and the problem isn’t confined to hospitals or other institutional settings. Simple infections of the skin, urinary tract, ear and lungs are increasingly more stubborn to cure and often require stronger antibiotics than in the past or require combinations of drugs.
New strains of the most well known superbug, MRSA (Methicillin-resistant Staph aureus), are attacking people outside of health care facilities and causing very aggressive infections that are difficult to cure.
The U.S. Centers for Disease Control and Prevention (the CDC) in 2010 estimated that MRSA caused serious infections in over 82,000 patients and killed over 11,000 of them. It has been noted that the elderly are the most susceptible to contracting a superbug.
So just how have we humans allowed these tiny organisms to get stronger and become so difficult to battle? The simple answer is that we’ve saturated our environment with antibiotics, the same amazing drugs that were created to fight bacterial infections. And it’s not just healthcare professionals who are to blame.
While over 7 million pounds of antibiotics are sold for human use each year, over  29 million pounds are sold for use in food animals. Experts argue that animal injections or adding antibiotics to feed stock represent a gross overuse of antibiotic drugs and that this makes the drugs less likely to work when we need them the most.
29 million pounds are sold for use in food animals. Experts argue that animal injections or adding antibiotics to feed stock represent a gross overuse of antibiotic drugs and that this makes the drugs less likely to work when we need them the most.
Bacteria exist in astronomical numbers in our environment. They reproduce rapidly and evolve readily to pass genetic traits—including antibiotic resistance—to succeeding generations as well as to other bacteria. The more bacteria encounter an antibiotic, the more readily they cultivate hardier versions of themselves capable of overcoming a drug attack.
Researchers tell us that there are several actions that can be taken to minimize bacterial antibiotic resistance:
1) Make sure your doctor knows that you only want an antibiotic if it’s absolutely necessary. Inappropriate prescription use for simple coughs and colds are the number one problem area for antibiotic use. Medical professionals estimate that only one in five infections require antibiotics. The great majority of infections are due to viruses, not bacteria, and an antibiotic is ineffective against viruses.
are the number one problem area for antibiotic use. Medical professionals estimate that only one in five infections require antibiotics. The great majority of infections are due to viruses, not bacteria, and an antibiotic is ineffective against viruses.
2) When appropriately prescribed an antibiotic, take all the medication—even if you feel better. In that way, the drug will completely eradicate the offending bacteria rather than merely weaken the organisms.
3) Consider buying meat raised without antibiotic use. Experts agree that less antibiotics in food animals will slow the development of resistant bacteria.
4) Use simple soap and water frequently to clean hands rather than an antibacterial soap or cleanser. Just as with animal feeds, the use of antibiotics in cleansers can foster the emergence of resistant bacteria.
Increased casual use of antibiotics is a global phenomenon, and it causes a greater degree of bacterial resistance to currently available antibiotic therapies.
SUPERBUGS are on the rise! Resistance is produced and enhanced by the misuse of antibiotics.
The simple solution is to remove indiscriminate use of antibiotics from our environment, and that’s a responsibility our government, agricultural and healthcare professionals must shoulder. But we, as individuals, must share some of that responsibility.
Thoughts? Comments? I’d love to hear them!

Jim,
Dang, you can be depressing.
Isn’t this just another version of the castle vs. cannon problem? Engineers build castles with stronger walls. Other engineers build cannons capable of sending heavier rocks more accurately and faster, and how to make the rock explode when it hits something hard.
So far, we have spent decades making the cannon balls more effective, stronger antibiotics, while the bacteria have been building stronger walls.
So maybe the analogy is more the river-side fort against the naval vessel — both are shooting at the other. We have concentrated on our cannon and have neglected making our defenses stronger.
If we stopped cold-turkey giving antibiotics to cows, for example, after some number of years we would have bacteria-resistant cows. Of course it is not that simple and there is not just one bacteria, but it could at least slow down the problem and perhaps make it manageable.
Walt.
Ha! Don’t mean to depress you, but sometimes reality really does bite! Thanks for that interesting analogy of the human-bacteria battle being another castle-cannon battle. Never thought about it like that, but it is a constant battle to stay ahead of evolving bacteria, just like our forefathers kept building better fortresses.
Isn’t the castles and cannons analogy false, though, exactly because we haven’t been developing new cannons? I would need to check this, but I don’t think there’s been a new class of antibiotics since the 1980s, while bacteria has steadily been evolving new defenses to the antibiotics that we do have.
Eddie,
The cannon vs. castles or forts analogy may be completely false. After all, in that case both sides are “sentient” and deliberately working on enhancements. In the bacteria case, at least one side is not, we think, self aware, but working on a perhaps more pressing drive, aka Darwinism. Also, there were many decades and sometimes centuries between new advances. Consider the English (or Welsh) longbow. It had great success at the start of the hundred years war with France (battle of Crecy in 1346), but was completely routed in the battle of Patay in 1429. Thirty years seems far too short of time to rule out the analogy.
Walt.
Again, making a comparison in timelines between the history of warfare and the history of antibiotic resistance doesn’t work.
Antibiotics were discovered in the 1920s, so less than a hundred years ago, at which time the bacterial castles started to be fortified. However, if no new antibiotics have been introduced in 30 years, that’s 1/3 of the entire struggle where the cannons haven’t been improved (equivalent to one sides’ weapons being 2000 years old in your timeline).
The point I was making was that it would be better *if* it were a cannons and castles situation, because right now only one side is making advancement. There was a BBC article recently (I think it was BBC) that said there isn’t a lot of incentive for drugs companies to research and make antibiotics, because antibiotics already exist and, generally, a person takes them once, is cured of the infection and doesn’t take them again. Long-term medication that someone takes over a period of time, or even life, is a far more attractive option.
It will be a dire shame on humankind if the real incentive to make them only comes when we reach a critical “antibiotic armegeddon” scenario.
So true, Eddie, regarding your comment about the real incentive for new drug development. The incentive for Big Pharma to create long-term, or so-called “maintenance medications”, is because of the greater return on investment than for less-often-used, cutting-edge pharmaceuticals. With less government and university research dollars available, far less “altruistic” drugs are being developed. Fortunately, however, a few innovative antibiotics are in the testing phase and, hopefully, will make it to the market in the not-to-distant future. Thanks for commenting.
So, even though we are circumspect in our individual use, the greater environment can stack the deck against us. The old adage that a little bit of dirt is good for us is truer than we all knew!
I tried to tell my wife that I shouldn’t shower every day (that it was creating antibacterial-resistant bacteria), but somehow she doesn’t agree. She said to take my advice about using plain soap and water. Hmm, guess I’ll take her advice.
Israel super bug medical cure developed http://youtu.be/M24_ZaIs0OY
Be sure to read tomorrow’s blog! Thanks for the input, but the battle is not won yet!